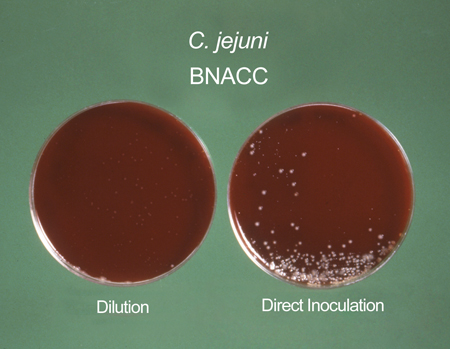

History and physical examination
A full history should be taken, including exposure to poultry, cattle, sheep, or other farm animals; eating raw or undercooked meat (especially chicken); recent foreign travel to high-risk areas, including Africa, South America, and Asia; and travel to developing countries.[14]Centers for Disease Control and Prevention. CDC Yellow Book 2024: traveler's health. Section 5: travel-associated infections & diseases - campylobacteriosis. May 2023 [internet publication].
https://wwwnc.cdc.gov/travel/yellowbook/2024/infections-diseases/campylobacteriosis
History of drinking untreated water, and drinking unpasteurised milk should also be noted.[26]Guzman-Herrador B, Carlander A, Etelberg S, et al. Waterborne outbreaks in the Nordic countries, 1998 to 2012. Euro Surveill. 2015 Jun 18;20(24):21160.
https://www.eurosurveillance.org/content/10.2807/1560-7917.ES2015.20.24.21160
http://www.ncbi.nlm.nih.gov/pubmed/26111239?tool=bestpractice.com
[27]Hinnenkamp R, Sorenson S, Evanson E, et al. Notes from the field: campylobacteriosis outbreak associated with consumption of raw water - Montana, 2022. MMWR Morb Mortal Wkly Rep 2023;72:411-2.
https://www.cdc.gov/mmwr/volumes/72/wr/mm7215a6.htm?s_cid=mm7215a6_w#suggestedcitation
[28]Shane AL, Mody RK, Crump JA, et al. 2017 Infectious Diseases Society of America clinical practice guidelines for the diagnosis and management of infectious diarrhea. Clin Infect Dis. 2017 Nov 29;65(12):e45-80.
https://academic.oup.com/cid/article/65/12/e45/4557073
http://www.ncbi.nlm.nih.gov/pubmed/29053792?tool=bestpractice.com
In immunocompetent people, illness typically occurs within 2 to 4 days after exposure to the organism in contaminated food or drink, although ranges from 1 to 10 days after exposure are described.[6]World Health Organization. Campylobacter fact sheet. 1 May 2020 [internet publication].
https://www.who.int/news-room/fact-sheets/detail/campylobacter
[14]Centers for Disease Control and Prevention. CDC Yellow Book 2024: traveler's health. Section 5: travel-associated infections & diseases - campylobacteriosis. May 2023 [internet publication].
https://wwwnc.cdc.gov/travel/yellowbook/2024/infections-diseases/campylobacteriosis
Many Campylobacter jejuni infections are sub-clinical, especially in immunocompetent people.[31]Havelaar AH, van Pelt W, Ang CW et al. Immunity to Campylobacter: its role in risk assessment and epidemiology. Crit Rev Microbiol. 2009;35(1):1-22.
http://www.ncbi.nlm.nih.gov/pubmed/19514906?tool=bestpractice.com
A history of HIV infection should be considered because the incidence of Campylobacter infection is increased in patients with HIV/AIDS, although the incidence is lower in HIV-positive patients on antiretroviral therapy.[5]Fernández-Cruz A, Muñoz P, Mohedano R, et al. Campylobacter bacteremia: clinical characteristics, incidence, and outcome over 23 years. Medicine (Baltimore). 2010 Sep;89(5):319-30.
http://www.ncbi.nlm.nih.gov/pubmed/20827109?tool=bestpractice.com
People with HIV are also at risk of becoming long-term carriers ofCampylobacter. This is associated with recurrent enteritis and bacteraemia.[25]Sorvillo FJ, Lieb LE, Waterman SH. Incidence of campylobacteriosis among patients with AIDS in Los Angeles County. J Acquir Immune Defic Syndr. 1991;4(6):598-602.
http://www.ncbi.nlm.nih.gov/pubmed/2023099?tool=bestpractice.com
The major clinical manifestations are diarrhoea and abdominal pain. Diarrhoea is often watery, with up to 8-10 bowel movements daily. It becomes bloody in approximately 20% to 25% of cases. Diarrhoea is considered inflammatory because of the prominent expression of fever and constitutional symptoms, and because the stools contain leukocytes and blood.[4]Blaser MJ. Epidemiologic and clinical features of Campylobacter jejuni infections. J Infect Dis. 1997 Dec;176(suppl 2):S103-5.
https://academic.oup.com/jid/article/176/Supplement_2/S103/841617
http://www.ncbi.nlm.nih.gov/pubmed/9396691?tool=bestpractice.com
Abdominal pain associated with Campylobacter infection is usually more severe than in the other bacterial causes of enteritis/colitis. The pain often becomes continuous and radiates to the right iliac fossa (frequently described as right lower quadrant pain by patients).[32]Same RG, Tamma PD. Campylobacter infections in children. Pediatr Rev. 2018 Nov;39(11):533-41.
https://www.ncbi.nlm.nih.gov/pmc/articles/PMC6657695
http://www.ncbi.nlm.nih.gov/pubmed/30385582?tool=bestpractice.com
Less-frequent symptoms include vomiting and a prodrome consisting of headache, myalgias, chills, and fever. One third of patients will have a prodrome that lasts 24 hours before the onset of diarrhoea. Vomiting is most common in infants.[32]Same RG, Tamma PD. Campylobacter infections in children. Pediatr Rev. 2018 Nov;39(11):533-41.
https://www.ncbi.nlm.nih.gov/pmc/articles/PMC6657695
http://www.ncbi.nlm.nih.gov/pubmed/30385582?tool=bestpractice.com
While research has shown that there is an inverse relationship between advancing age and the typical Campylobacter presentation, there is a direct relationship between severity of illness and advancing age.[33]White AE, Ciampa N, Chen Y, et al. Characteristics of Campylobacter and salmonella infections and acute gastroenteritis in older adults in Australia, Canada, and the United States. Clin Infect Dis. 2019 Oct 15;69(9):1545-52.
https://www.ncbi.nlm.nih.gov/pmc/articles/PMC6606397
http://www.ncbi.nlm.nih.gov/pubmed/30602004?tool=bestpractice.com
Rare extra-intestinal manifestations include: perinatal infection, bacteraemia, meningitis, spontaneous peritonitis, cholecystitis, endocarditis, pancreatitis, cystitis, cellulitis, hepatitis, interstitial nephritis, placental infection, septic abortion, septic arthritis, septic thrombophlebitis, pneumonia, lung abscess, and empyema.[5]Fernández-Cruz A, Muñoz P, Mohedano R, et al. Campylobacter bacteremia: clinical characteristics, incidence, and outcome over 23 years. Medicine (Baltimore). 2010 Sep;89(5):319-30.
http://www.ncbi.nlm.nih.gov/pubmed/20827109?tool=bestpractice.com
Initial investigations
Stool samples should be collected for microscopy and culture as part of the initial investigation in all patients with suspected Campylobacter infection. A positive stool culture for Campylobacter is diagnostic.[14]Centers for Disease Control and Prevention. CDC Yellow Book 2024: traveler's health. Section 5: travel-associated infections & diseases - campylobacteriosis. May 2023 [internet publication].
https://wwwnc.cdc.gov/travel/yellowbook/2024/infections-diseases/campylobacteriosis
Stool samples should be examined for red blood cells and neutrophils, which are present in the majority of patients with Campylobacter infection.[4]Blaser MJ. Epidemiologic and clinical features of Campylobacter jejuni infections. J Infect Dis. 1997 Dec;176(suppl 2):S103-5.
https://academic.oup.com/jid/article/176/Supplement_2/S103/841617
http://www.ncbi.nlm.nih.gov/pubmed/9396691?tool=bestpractice.com
[34]Tribble DR, Baqar S, Scott DA, et al. Assessment of the duration of protection in Campylobacter jejuni experimental infection in humans. Infect Immun. 2010 Apr;78(4):1750-9.
https://journals.asm.org/doi/10.1128/iai.01021-09
http://www.ncbi.nlm.nih.gov/pubmed/20086085?tool=bestpractice.com
[35]Cover TL, Perez-Perez GI, Blaser MJ. Evaluation of cytotoxic activity in fecal filtrates from patients with Campylobacter jejuni or Campylobacter coli enteritis. FEMS Microbiol Lett. 1990 Aug;58(3):301-4.
https://academic.oup.com/femsle/article/70/3/301/835580?login=false
http://www.ncbi.nlm.nih.gov/pubmed/2227365?tool=bestpractice.com
Current Canadian guidelines for investigating suspected infectious diarrhoea suggest that stool testing is not required in most cases of acute (≤7 days) or resolving diarrhoea.[36]Government of British Columbia. Infectious diarrhea - guideline for investigation. Dec 2023 [internet publication].
https://www2.gov.bc.ca/gov/content/health/practitioner-professional-resources/bc-guidelines/infectious-diarrhea-guideline-for-investigation
The guideline recommends that the Infectious Diarrhea Panel, a new stool test that combines stool cultures, ova and parasites, and Clostridium difficile, should be requested if diarrhoea is severe of any duration or prolonged >7 days.[36]Government of British Columbia. Infectious diarrhea - guideline for investigation. Dec 2023 [internet publication].
https://www2.gov.bc.ca/gov/content/health/practitioner-professional-resources/bc-guidelines/infectious-diarrhea-guideline-for-investigation
Isolation techniques and special media (Campy-BAP or Skirrow) are used to reduce the growth of other enteric organisms. Specific selective media and raised incubation temperatures are required to isolate Campylobacter species.[Figure caption and citation for the preceding image starts]: Campylobacter cultures grown on Skirrow's and Butzler's mediumSheila Mitchell, Image Library, US Centers for Disease Control and Prevention [Citation ends].
Patients with late-onset complications from Campylobacter infection (e.g., bacteraemia, cardiac complications, extra-intestinal manifestations, reactive arthritis, and Guillain-Barre syndrome) may have negative stools, either due to loss of the bacteria or because of antimicrobial treatment. In these patients, a serological test can be used to detect antibodies to Campylobacter to indicate exposure.[4]Blaser MJ. Epidemiologic and clinical features of Campylobacter jejuni infections. J Infect Dis. 1997 Dec;176(suppl 2):S103-5.
https://academic.oup.com/jid/article/176/Supplement_2/S103/841617
http://www.ncbi.nlm.nih.gov/pubmed/9396691?tool=bestpractice.com
[37]Schmidt-Ott R, Schmidt H, Feldmann S, et al. Improved serological diagnosis stresses the major role of Campylobacter jejuni in triggering Guillain-Barré syndrome. Clin Vaccine Immunol. 2006 Jul;13(7):779-83.
https://journals.asm.org/doi/10.1128/cvi.00065-06
http://www.ncbi.nlm.nih.gov/pubmed/16829615?tool=bestpractice.com
Blood culture can isolate Campylobacter species as bacteraemia can transiently occur in the early stages of infection.[38]O'Hara GA, Fitchett JRA, Klein JL. Campylobacter bacteremia in London: a 44-year single-center study. Diagn Microbiol Infect Dis. 2017 Sep;89(1):67-71.
http://www.ncbi.nlm.nih.gov/pubmed/28629878?tool=bestpractice.com
Blood culture is not recommended as an initial test in people with features of Campylobacter infection, because the diagnosis can usually be made by stool culture alone. Symptoms of bacteraemia or other extra-intestinal manifestations do warrant additional investigation with blood cultures.
White blood cell count is often normal in cases of Campylobacter infection, but a left shift (increase in neutrophil predominance) may occur.[34]Tribble DR, Baqar S, Scott DA, et al. Assessment of the duration of protection in Campylobacter jejuni experimental infection in humans. Infect Immun. 2010 Apr;78(4):1750-9.
https://journals.asm.org/doi/10.1128/iai.01021-09
http://www.ncbi.nlm.nih.gov/pubmed/20086085?tool=bestpractice.com
Campylobacter infection may be associated with lymphopenia.[39]Herbinger KH, Hanus I, Beissner M, et al. Lymphocytosis and lymphopenia induced by imported infectious diseases: a controlled cross-sectional study of 17,229 diseased German travelers returning from the tropics and subtropics. Am J Trop Med Hyg. 2016 Jun 1;94(6):1385-91.
https://www.ncbi.nlm.nih.gov/pmc/articles/PMC4889762
http://www.ncbi.nlm.nih.gov/pubmed/27068397?tool=bestpractice.com